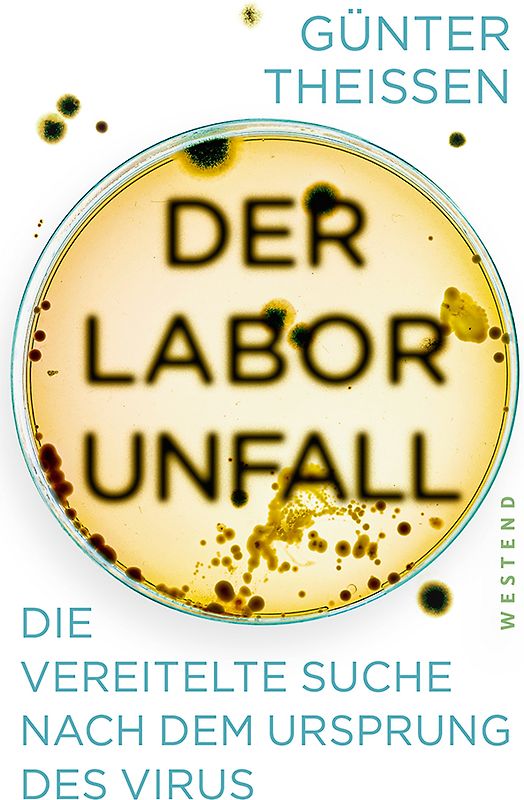
Das Virus

iPhoneAlle anzeigen
iPhone 11iPhone 11 ProiPhone 11 Pro MaxiPhone 12iPhone 12 ProiPhone 12 Pro MaxiPhone 12 miniiPhone 13iPhone 13 ProiPhone 13 Pro MaxiPhone 13 miniiPhone 14iPhone 14 PlusiPhone 14 ProiPhone 14 Pro MaxiPhone 15iPhone 15 PlusiPhone 15 ProiPhone 15 Pro MaxiPhone 16iPhone 16 PlusiPhone 16 ProiPhone 16 Pro MaxiPhone 16eiPhone 8iPhone 8 PlusiPhone SE 2020iPhone SE 2022iPhone XiPhone XRiPhone XSiPhone XS Max
Galaxy A-SerieAlle anzeigen
Galaxy A12Galaxy A13Galaxy A13 5GGalaxy A14Galaxy A15Galaxy A16Galaxy A17 5GGalaxy A20eGalaxy A21Galaxy A22Galaxy A23Galaxy A24Galaxy A25Galaxy A26 5GGalaxy A32Galaxy A33Galaxy A34Galaxy A35Galaxy A36 5GGalaxy A40Galaxy A41Galaxy A42Galaxy A50Galaxy A51Galaxy A52Galaxy A53Galaxy A54Galaxy A55Galaxy A56 5GGalaxy A70Galaxy A71Galaxy A72
Redmi SeriesAlle anzeigen
Redmi 10Redmi 13CRedmi 15 5GRedmi Note 10Redmi Note 10 ProRedmi Note 11Redmi Note 11 ProRedmi Note 11 Pro Plus 5GRedmi Note 11sRedmi Note 12Redmi Note 12 5GRedmi Note 12 ProRedmi Note 12 Pro 5GRedmi Note 12 Pro PlusRedmi Note 13Redmi Note 13 5GRedmi Note 13 ProRedmi Note 13 Pro PlusRedmi Note 14Redmi Note 14 Pro PlusRedmi Note 8Redmi Note 8 ProRedmi Note 9Redmi Note 9 Pro
-62 %*
Handgeprüfte Gebrauchtware
Bis zu 50 % günstiger als neu
Der Umwelt zuliebe
Optischer Zustand
Exzellenter Zustand Keine oder nur minimale Gebrauchsspuren vorhanden Ohne Knicke, Markierungen Bestens als Geschenk geeignet
Beschreibung
SARS-CoV-2 hält seit über zwei Jahren die Welt in Atem. Doch wo liegt der Ursprung des Virus und wie genau ist es entstanden? Wie ein Kriminalkommissar hat sich der erfahrene Molekularbiologe Günter Theißen auf Spurensuche begeben und seit Anbeginn der Pandemie alle verfügbaren Fakten zusammengetragen. Schon bald musste er jedoch feststellen, dass sich die Mehrzahl der Fachleute und ein Großteil… der Medien auf eine rein natürliche Entstehung des Virus festgelegt haben - ohne hieb- und stichfeste Beweise! Warum besteht so wenig Interesse daran, die Wahrheit zu erfahren? Zusammen mit gleichgesinnten Kollegen setzt sich Theißen für eine vorurteilsfreie Aufklärung der Entstehung des Virus und eine unabhängige Wissenschaft ein. Die Widerstände, die sich dieser kritischen Suche in den Weg stellen, offenbaren die akuten Schwachstellen unserer Wissenschaftskultur, der Medienlandschaft und der internationalen Politik. neu 20,00 € -62 %*
7,49 €
zzgl.
zzgl.
Handgeprüfte Gebrauchtware
Bis zu 50 % günstiger als neu
Der Umwelt zuliebe
* Spare 62 % gegenüber Neuware
Der Streichpreis bezieht sich auf den festgelegten Preis für Neuware.
Technische Daten
Erscheinungsdatum
07.06.2022
Sprache
Deutsch
Originalsprache
Deutsch
EAN
9783864893728
Herausgeber
Westend
Sonderedition
Nein
Autor
Günter Theißen
Seitenanzahl
192
Auflage
1
Einbandart
Broschiert
-.-
★★★★★
☆☆☆☆☆ Leider noch keine Bewertungen
Leider noch keine Bewertungen
Sicher bei rebuy kaufen
Schreib die erste Bewertung für dieses Produkt!
Wenn du eine Bewertung für dieses Produkt schreibst, hilfst du allen Kund:innen, die noch überlegen, ob sie das Produkt kaufen wollen. Vielen Dank, dass du mitmachst!
Sicher bei rebuy kaufen

